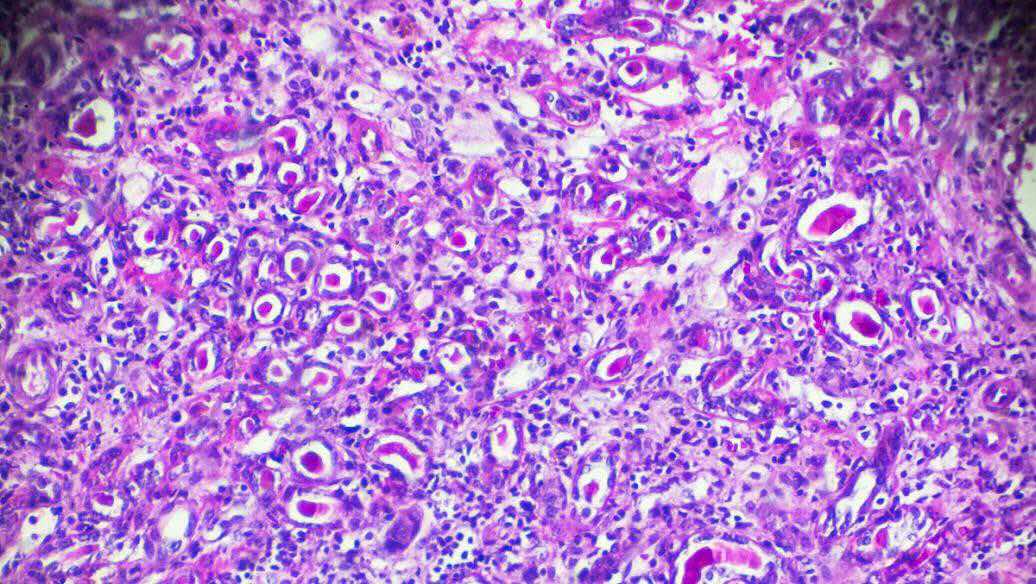
微信图片_20201023132059.jpg

加州大学洛杉矶分校的研究人员已经确定了一种化合物,该化合物可以在小鼠的肌肉细胞中复制运动的效果。研究结果发表在“细胞报告医学”杂志上。
通常,由于肌肉细胞内部的一系列化学信号,肌肉在使用时会变得更强壮。新发现的化合物激活了这些信号,这表明类似的化合物最终可以用于治疗患有四肢腰肌营养不良的人,这是一种青少年期肌肉营养不良的形式。
当肌肉不能正常工作时,它们会逐渐萎缩。(这种现象对腿部施法已有数周的人都是熟悉的。)幸运的是,对于肌肉健康的人来说,这种恶化是可逆的。肌肉使用会刺激肌肉细胞内部的化学信使,从而增加肌肉质量和力量。
患有肌肉萎缩疾病的人肢带肌营养不良症有遗传缺陷,会干扰该化学信使,使他们的肌肉无法对运动做出反应。没有任何运动可以触发增强肌肉的信号。由于肌肉永远无法获得信息,因此它们逐渐枯萎,患有这种疾病的人最终坐在轮椅上几乎完全瘫痪。
该论文的资深作者,加州大学洛杉矶分校(UCLA)Eli and Edythe Broad再生医学和干细胞研究中心的成员梅利莎·斯宾塞(Melissa Spencer)表示:“这确实非常引人注目。当这些患者失去肌肉时,他们就难以恢复肌肉。”
导致四肢带状肌营养不良的遗传缺陷导致称为CaMK的肌肉细胞缺乏一种酶。CaMK负责发射一系列化学信号,这些信号打开基因以增强细胞生长和代谢脂肪的能力,而脂肪被用作能源。
斯潘塞说:“ CaMK激活了促进肌肉生长和脂肪代谢的基因,”他也是加州大学洛杉矶分校戴维·格芬医学院的神经学教授兼神经肌肉计划主任。
为了找到一种可以帮助恢复与CaMK有关的信号的药物,Spencer和她的同事与UCLA分子共享筛选资源总监Robert Damoiseaux一起筛选了2,000多种化合物,以查看哪些化合物在实验室生长的肌肉细胞中起作用。到目前为止,他们已经在小鼠中测试了14种有希望的候选者,这些候选者的遗传缺陷与导致人肢带肌营养不良的小鼠相当。
测试确定了一种叫做AMBMP的化合物,它可以使小鼠的肌肉工作并以健康的肌肉细胞的方式生长。
斯宾塞说:“当我们将这种药物放入小鼠体内时,我们发现它激活了CaMK,并恢复了我们在疾病模型中观察到的所有缺陷。”
Spencer和她的合作者正在计划进一步的研究,以了解AMBMP如何影响CaMK并确定对人体更有效的类似化合物。



